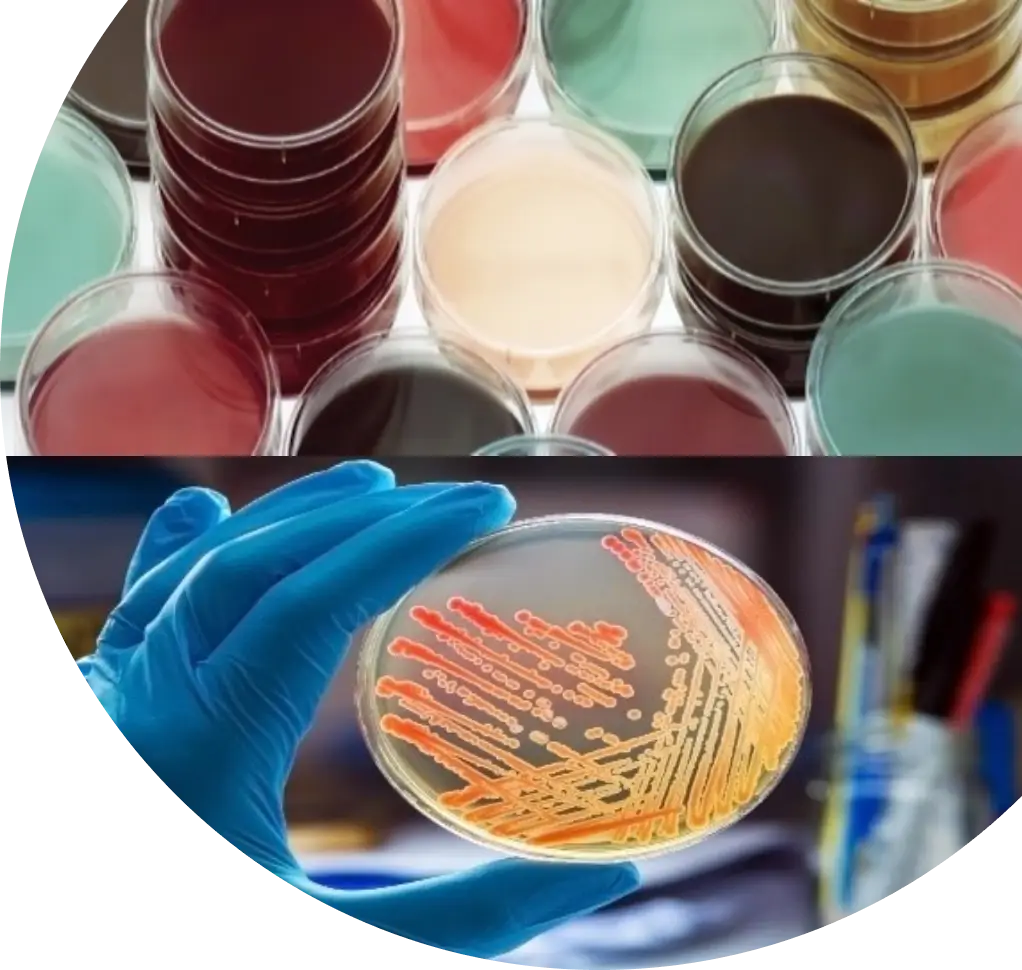
image

Ready to Use Media Plates
Sterile 55/90/100 mm agar plates for accurate microbiological analysis.
Delivering contamination-free, high-performance microbiology media&consumables for hospitals, diagnostic labs, research centers, and industries.
Contact Us

Bhat Bio-Media, a division of Bhat Bio-Tech India Pvt. Ltd., is a trusted manufacturer and supplier of high-quality ready-to-use microbiological media for hospitals, diagnostic labs, research centers, and industries. Our products are developed under stringent GMP and ISO standards, ensuring consistency, accuracy, and reliability in every batch.









Strict protocols and internationally recognised standards ensure reliability and safety in every product.

Every batch undergoes rigorous sterility, pH, moisture, and ATCC strain performance checks for consistency.

From ready-to-use culture media to diagnostic reagents and dehydrated media—one-stop solutions for labs.

Serving clinical, academic, and industrial labs with consistent quality, fast delivery, and excellent support.
© Copyright 2025 - Bhat Bio Media | Powered by Channel Softech

Typically replies instantly